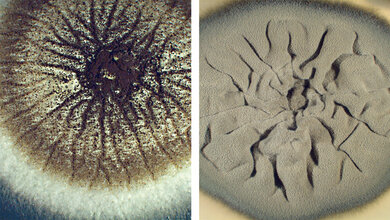
Schimmelpilze Teil 1: Dematiaceae

Wie entstehen hochresistente Pilzstämme?
Bei Cryptococcus neoformans handelt es sich um einen hefeähnlichen Pilz, der Menschen infizieren kann. Zur Behandlung stehen zwar Antimykotika zur Verfügung, die aber nicht immer wirken – ein ähnliches Phänomen wie bei der Antibiotikaresistenz. Ein Team der US-amerikanischen Duke University und der Ruhr-Universität Bochum (RUB) hat mit genetischen, bioinformatorischen und mikrobiologischen Techniken den Mechanismus dieser Resistenz entschlüsselt.
Verantwortlich für Kryptokokkose
„Die Ergebnisse sind von hoher Relevanz für die Bekämpfung von pilzlichen Infektionen in der klinischen Praxis, in der Veterinärmedizin und der Agrarwirtschaft“, so Prof. Dr. Ulrich Kück, Seniorprofessor in der Allgemeinen und Molekularen Botanik der RUB. Er kooperierte für die Arbeiten mit dem Bochumer Forscher Dr. Tim Dahlmann sowie dem Team um Prof. Dr. Joe Heitman, der derzeit an der Duke University in North Carolina tätig ist. „In der westlichen Hemisphäre steigt die Zahl der Menschen mit einer verminderten Immunabwehr, weil die Lebenserwartungen stark steigen oder die Behandlung mit Immunsuppressiva nach Organtransplantationen zunimmt“, erklärt Ulrich Kück. „Damit verbunden steigen pilzliche Infektionen.“ Cryptococcus neoformans gehört zu den bedeutenden humanpathogenen Pilzen, der für die sogenannte Kryptokokkose verantwortlich ist. Er löst bei immungeschwächten Patientinnen und Patienten akute Infektionen aus; die Sterberate liegt bei bis zu 70 Prozent. Denn in der Klinik entwickeln sich häufig Pilzstämme, die resistent gegen die Medikamente sind, was die Behandlung erschwert. Bisher war unklar, welche zellulären und genetischen Mechanismen zu diesen Resistenzen führen.
Transposonen spielen Rolle
Bekannt war jedoch, dass sogenannte Transposonen eine Rolle bei den Resistenzen spielen. Dabei handelt es sich um springende Gene, also DNA-Abschnitte, die ihre Position im Erbgut verändern und so die Funktion von Genen beeinflussen können. Springen die Transposonen in ein Gen, das für die Empfänglichkeit für ein Medikament wichtig ist, können Resistenzen entstehen. Die Beweglichkeit der Transposonen wird durch regulatorische RNAs kontrolliert, die als small interfering RNA, kurz siRNA, bezeichnet werden.
Abschaltung der siRNA-Kontrolle
In der aktuellen Arbeit entdeckten die Forschenden in resistenten Isolaten Genmutationen, die zur Abschaltung der siRNA-Kontrolle führten. Durch das Einbringen einer intakten Kopie des Gens, konnte die siRNA-Kontrolle wiederhergestellt werden, was das Springen der Transposonen verhinderte und die Ursache der Resistenzbildung aufklärte. Weil sie so klein sind, sind die Genabschnitte, die für siRNAs kodieren, nicht leicht im Erbgut zu finden. Tim Dahlmann gelang dies mit speziellen bioinformatischen Analysen. Die Aufklärung der Resistenzmechanismen könnte in Zukunft für die Behandlung von Mykosen beim Menschen genutzt werden.
Qelle: idw/RUB
Artikel teilen